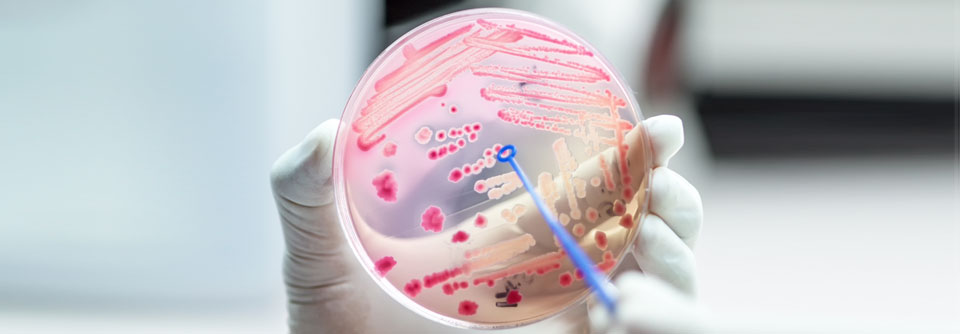

Tularämie Dank moderner Antibiotika ist die Prognose gut
 Das Tragen von angemessener Schutzkleidung beim Kontakt mit kranken und toten Wildtieren schützt am besten vor einer Infektion mit der Hasenpest.
© Jan – stock.adobe.com
Das Tragen von angemessener Schutzkleidung beim Kontakt mit kranken und toten Wildtieren schützt am besten vor einer Infektion mit der Hasenpest.
© Jan – stock.adobe.com
Auch stechende Insekten und Zecken können das intrazellulär wachsende Bakterium übertragen, schreiben Dr. Benjamin Arnold und Kollegen von der Klinik für Infektiologie und Tropenmedizin, Klinikum St. Georg in Leipzig. Gefährdet sind insbesondere Jäger, Förster, Präparatoren, Landwirte und Laborpersonal. Auch bei Freizeitaktivitäten oder über kontaminiertes Fleisch kann man mit dem Erreger in Kontakt kommen.
Nach einer Inkubationszeit von drei bis fünf Tagen klagen Betroffene anfänglich meist über uncharakteristische Beschwerden. Dazu zählen etwa Kopfschmerzen, Fieber und Schüttelfrost, häufig auch eine schmerzhafte Lymphadenopathie.
An der Eintrittspforte des Erregers entstehen Ulzera
Ty…
Bitte geben Sie Ihren Benutzernamen und Ihr Passwort ein, um sich an der Website anzumelden.